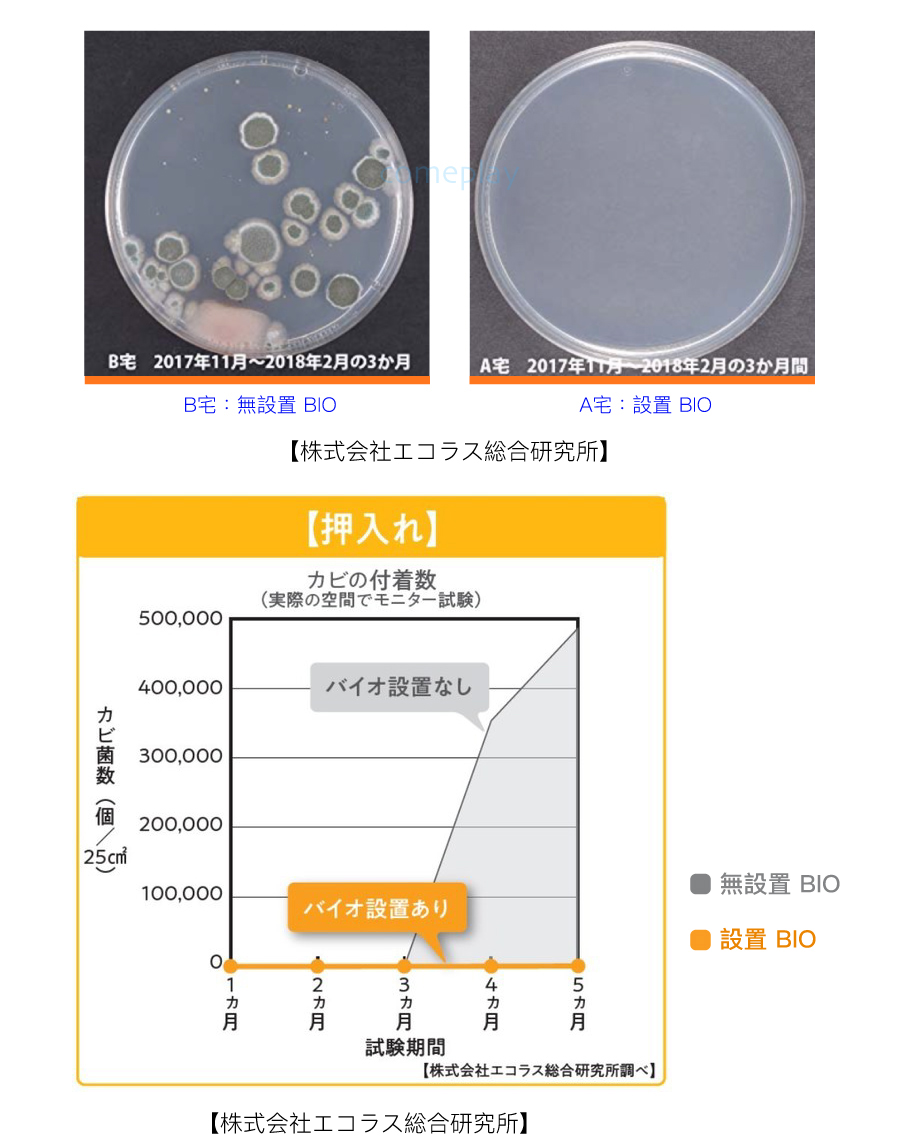

新一代 BIO,添加珪藻土成分,消臭防霉 Power Up !!
多雨潮濕的台灣,家中很容易孳生黴菌,危害身體健康。
【商品說明】
1. BIO 搭配珪藻土添加,24小時消臭防霉,減輕需經常刷洗的負擔。
2. BIO 以污垢或臭味的原生物質為食餌,然後在他們體內予以消化分解為
1. 二氧化碳與無機物。
3. 無需用電,無異味,無有害物質,給家人環保、安全無害的生活空間。
4. 比起上一代,新一代 BIO 優化了成分與配比,可對抗 5 種黴菌(黑黴、青黴、紅黴、
1. 麴黴、Aspergillus tonophilis 等……);可消除 4 種異味(氨、醋酸、三甲胺、
1. 硫化氫)。
5. 新增吊掛功能,可黏貼、吊掛使用。
6. 拆封後使用,有效期間約 4 個月左右。
【使用方式】
2. 1. 此商品用途主要是消臭與抑制黴菌再孳生,對現有的發霉現象不一定能
2. 4. 完全清除。若衣櫃已有發霉現象,建議先清除乾淨後後再使用本品。
2. 2. 黏貼使用:拆封後請撕開背面的雙面膠,貼在衣櫃高處層板下緣。
2. 4. 黏貼前請先用乾布將該位置上的水分與灰塵清除。黏貼位置可能因材質而
2. 4. 有無法黏貼的情形。
2. 3. 吊掛使用:將掛鉤自本體拉開,吊掛於衣櫃內的橫桿上、鐵架上、
2. 4. 牆壁掛鉤上。
2. 4. 適用於 1 座對開雙門衣櫃大小的空間,如更大之衣櫃,建議使用
2. 4. 本產品 2 個或更多,依此類推。
2. 5. 一盒 1 入。拆封後,請在貼紙上用油性筆寫上當天日期,並黏貼在本體上,
2. 4. 以便 4 個月後更換。
2. 6. 內附貼紙可寫上預定更換日期(自拆開塑膠袋後起算 4 個月)。
BIO 是什麼?
BIO 是一種微生物,可將發霉及惡臭的原生物當食餌,將之分解為賴以為生的營養素,再排出二氧化碳和無機物質。
除了防霉之外,顯著的消臭效果也是經過證實的。
是日本許多家庭都會使用的防霉消臭商品。
於專門的實驗室進行研究,經過精密的測試與實驗。
使用前使用後實驗結果。
拆封後約可使用 4 個月。
【商品規格】
內容物:本體、交換日期貼紙、雙面膠帶
使用效期:每片拆封後約可使用 4 個月左右
保存期限:未拆封後約可保存 3 年
材質成分:珪藻土、微生物(芽孢桿菌屬)/ 盒子:聚丙烯(PP)
產品尺寸:8.5 x 8.5 cm,厚 0.9 cm(掛勾收起時)
包裝尺寸/重量:14 x 10.5 x 2.2 cm / 約 40 g
品牌:COGIT
產地:日本
【使用注意】
● 請置於小朋友無法取得的位置。
● 產品的特性所致,剛開封設置時會有產品特有的味道。使用一段時間後
● 味道即會變淡。但並不影響產品本身的品質。
● 效果、持續時間根據不同使用狀況而有些差異。
● BIO 是微生物,它的活動與使用的環境有關,效果也與使用狀況有關。
● 在惡臭或是髒汙的有機物質異常繁多的環境下使用,會造成臭味的有機物
● 增加,呈現的效果會較慢。
● 使用本產品時,請勿與強酸性及強鹼性的清潔劑,或高抗菌、殺菌的商品
● 合併使用,以免微生物滅亡。並請避免與其他抗菌產品一同使用。
● 使用期間請不要進行衣櫃的消毒或是殺菌。
● 本產品可抑制黴菌的繁殖及增生,但不能將巳發霉的現象去除,
● 亦無法去除黴菌的顏色。
● 建議黏貼於平面。若黏貼在凹凸表面或可能因貼附材質不同,需注意
● 有掉落的可能。
● 黏貼處若有雙面膠的殘留狀況時,可用市售的去膠產品清除。
● 請勿使用於其他目的。
● 本產品一旦經過拆封其效力就會開始發揮,如經拆封、使用,恕無法退換。
【備註】
BIO 有多款不同用途商品,成分雖相同,但配方比例、容量都根據使用空間與用途而有所不同。